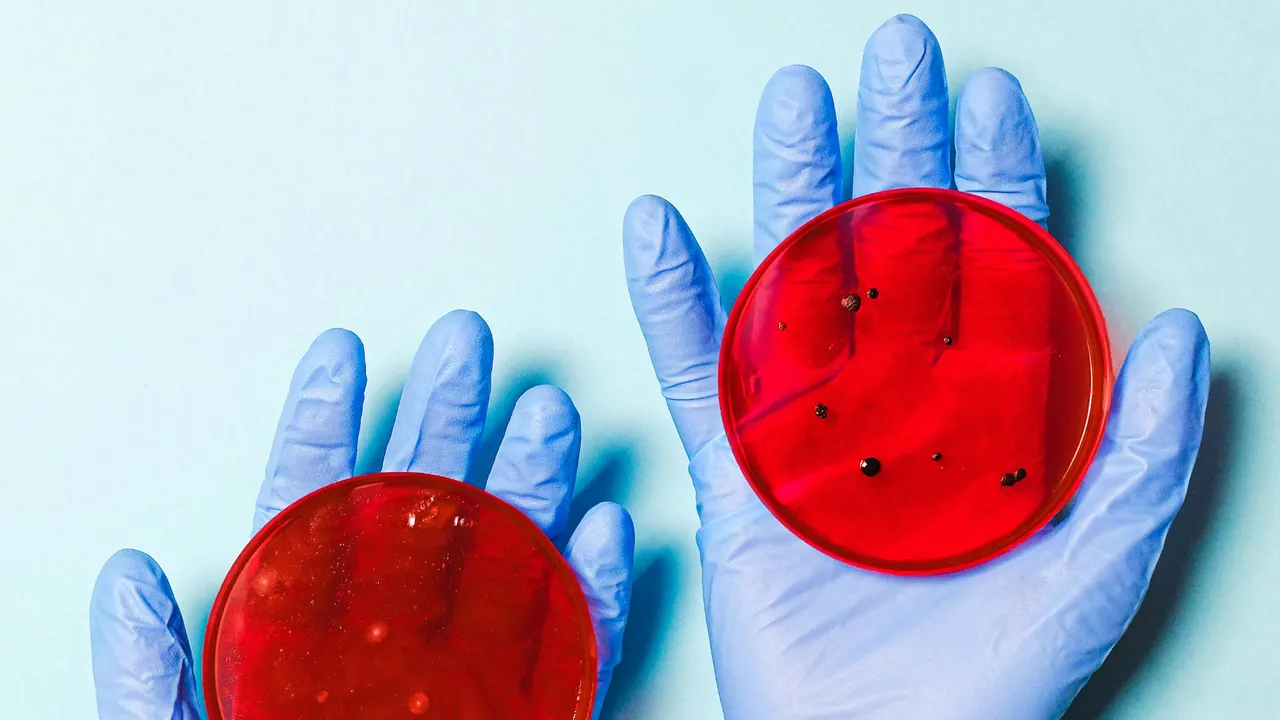
Mutasyonlu grip virüsü

İnfluenza A H3N2 virüsünün vakaları artıyor: Maskeler geri dönebilir!
Bu yılın başlarında ortaya çıkan ve 7 mutasyon geliştiren yeni bir "influenza A H3N2" virüsü varyantı küresel olarak endişeye neden oldu. "Subclade K" adı da verilen bu mutasyonlu H3N2 varyantı hızla yayıldı ve Türkiye de dahil olmak üzere Kuzey Yarımküre'deki birçok ülkede şimdiden baskın hale geldi. Bilim insanları oldukça bulaşıcı ve ağır hastalığa neden olan bu virüsün mevcut aşılardan kaçabileceğini hakkında uyardı ve maske takılmasını tavsiye etti. "Influenza A H3N2 nedir?", "Aşılar Influenza A H3N2'e karşı koruyabilir mi?", "Influenza A H3N2'in belirtileri nelerdir?" sorularının ve daha fazlasının cevabını bu haberde bulabilirsiniz.
"SERT BİR GRİP SEZONU KAPIDA"
ABD Ulusal Bulaşıcı Hastalıklar Vakfı Tıbbi Direktörü Dr. Robert Hopkins Jr.'ın aktardığına göre, bu yeni varyant Japonya'da alışılmadık derecede erken ve sert bir grip sezonunun ardından, enfeksiyonlarda büyük bir artışa neden oldu ve ülke grip salgını ilan etti. Bununla birlikte, Subclade K suşu, sağlık yetkililerinin mutasyonlu H3N2 virüsü yayılırken İngiltere'yi de etkisi altına almış durumda bulunuyor.

Kanada'da da dolaşımda olan mutasyonlu varyant, bilim insanlarını mevcut 2025-2026 grip aşısındaki H3N2 ile, dünya çapında baskın suş haline gelmesi beklenen subclade K suşu arasındaki uyumsuzluk konusunda önlem almaya sevk etti. Global İnfluenza Veri Paylaşım Girişimi (GISAID) veritabanına göre, H3N2 subclade K, ABD eyaletlerinin yarısından fazlasında tespit edilmiş durumda. Hopkins, "Dışarıda yeni bir mutasyonlu varyant olduğunu ve H3N2'nin genellikle daha şiddetli hastalığa neden olduğunu bilmek endişe verici. Özellikle genç insanlar arasında hastalık şimdiden artışa geçti" açıklamasını yaptı.

AŞI YİNE DE ÖNEMLİ KORUMA SAĞLIYOR
ABD Johns Hopkins Bloomberg Halk Sağlığı Okulu'nda virolog olan Andrew Pekosz, H3N2 subclade K virüsünün yedi yeni mutasyona sahip olduğunu belirtiyor. Bu varyant, bilim insanları bu yılki grip aşısına dahil edilecek spesifik varyantları seçtikten sonra, Haziran ayında Avrupa'da tespit edildi. Bu nedenle aşı, bu mutasyonlu virüse karşı mükemmel bir koruma sağlamıyor.

Ancak uzmanlar, aşının grip sezonu boyunca hala koruma sağlayacağını vurguladı. Hopkins, "Aşıların amacı hastalığın şiddetini azaltmak ve hastalığın nüfusumuz üzerindeki etkisini azaltmaktır. Ayrıca, bu yılki aşının dolaşımdaki H1N1 ve influenza B iyi bir uyum sağlaması bekleniyor. H3N2 optimal olmasa bile, diğer iki grip varyantına karşı koruma elde edeceksiniz" ifadelerini kullandı.

AŞI İÇİN ÖNCELİK KİMLERDE?
Aşı, özellikle 65 yaş üstü kişiler, küçük çocuklar ve bağışıklığı baskılanmış veya altta yatan kronik rahatsızlıkları olanlar dahil olmak üzere yüksek riskli bireyler için kritik öneme sahip. Pekosz, bağışıklığın oluşması yaklaşık iki hafta sürdüğünden, aşıyı olmak için geç olmadığını belirtiyor.

MUTASYONLU H3NR GRİP VİRÜSÜNÜN BELİRTİLERİ NELERDİR?
Mutasyonlu H3N2 grip virüsünün belirtileri, uzmanların belirttiğine göre, mevsimlik influenza A varyantlarının neden olduğu semptomlara benzer görünüyor. Bunlar:
Ateş
Titreme
Vücut ağrıları
Baş ağrısı
Aşırı yorgunluk
Burun tıkanıklığı veya burun akıntısı
Öksürük

"KAMYON ÇARPMIŞ" HİSSİNE NEDEN OLUYOR
Hopkins, bu hastalığın belirtilerinin aniden başlama eğiliminde olduğunu ve "kamyon çarpmış" hissine neden olduğunu söyledi. Hopkins, "Belirtiler Covid-19 ve diğer virüslerin belirtilerine de benzeyebileceğinden, test yapılması önem taşıyor" dedi.

Son olarak Hopkins, solunum yolu virüsü sezonunda insanların kendilerini ve başkalarını koruması için basit önlemler alınmasını tavsiye etti. Bu öneriler ise şu şekilde:
Aşılarınızı güncel tutun.
Belirtileriniz varsa test yapın.
Pozitif çıkarsa, 24 saat veya ateşiniz düşene kadar kendinizi izole edin.
Hasta kişilerden kaçının.
Kalabalık, kapalı alanlarda maske takın.
Ellerinizi sık sık yıkayın.
Öksürük ve hapşırıklarınızı kapatın.
Güncellenme Tarihi : 7.12.2025 16:01